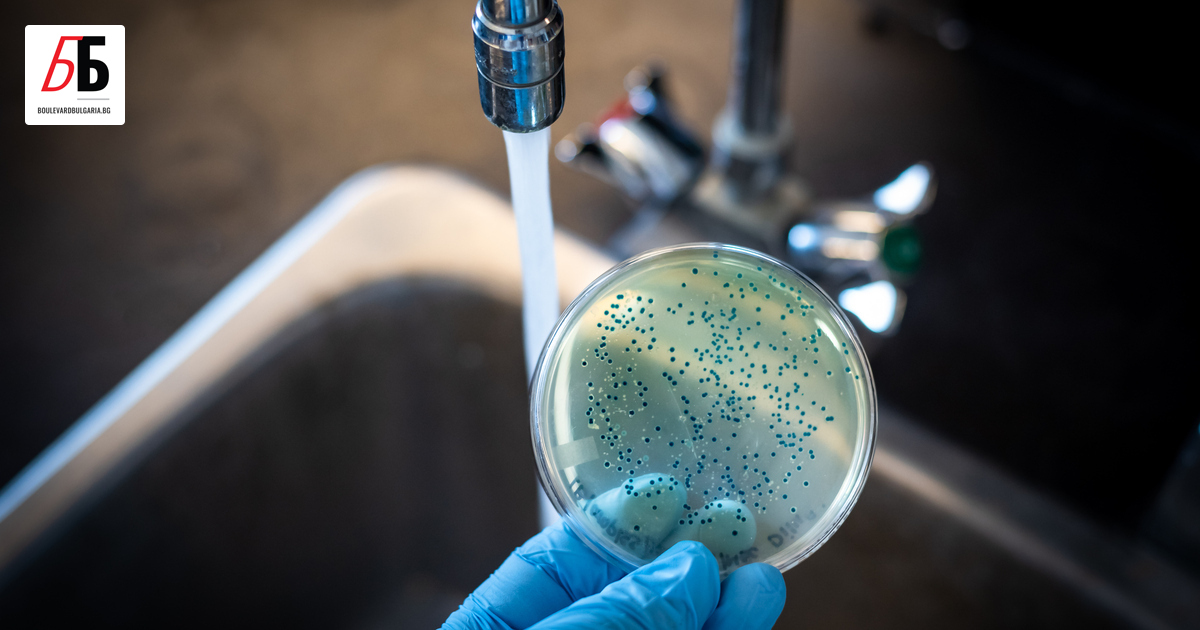
Внeсен случай на холера е регистриран в България за първи

Регистриран е първи случай на холера у нас от 103 г. насам - Булевард България
Внeсен случай на холера е регистриран в България за първи път от 103 години насам.
Става въпрос за 23-годишен индийски жител, живеещ у нас, който в интервала сред 13 август и 2 септември е бил в Ню Делхи, Индия, оповестяват от Министерството на здравеопазването.
За доказания случай рапортува столичната Регионална здравна ревизия (СРЗИ). Пациентът заболява на 3-ти септември заради остра диария, без демонстрация на други недоволства. Извършено е лабораторно проучване, което след това е доказано в Националната лаборатория по изключително рискови бактериални инфекции към Националния център по заразни и паразитни заболявания.
Заболелият е изолиран в стая със независим хигиеничен възел в СБАЛ по паразитни и инфекциозни заболявания „ Проф. Иван Киров “. Той е в положително общо положение.
Под наложителна карантина в същата болница е сложено и лице, с което болният съжителства, несъмнено от СРЗИ като непосредствен контактен. До момента той е без недоволства, като има негативен резултат от проучване и му е извършена антибиотична профилактика.
В хода на извършеното епидемиологично изследване няма открити други контактни лица.
Заболелият не е посещавал публични места, в това число заведения за хранене и други В лечебното заведение e връчено наставление за съблюдаване на прецизен противоепидемичен режим, засилена стерилизация, носене на персонални защитни средства от личния състав, за попречване разпространяването на болестта.
Холерата е извънредно заразно заболяване, излъчено посредством усвояване на нечиста храна или вода. Характеризира се с интоксикация, проваляне на тънкото черво, гастроинтестинални прояви, дехидратация, тежко протичане и висока смъртност.
Предаването на заболяването на хора става посредством консумация на инфектирана вода, храна и посредством нечисти ръце и предмети.
До началото на ХІХ век холерата е публикувана основно в Индия, като река Ганг е главният източник на болестта. От 20-те години на ХІХ век заболяването се популяризира и в други страни, като провокира пандемии с милиони жертви.
В България холерата е била сериозен проблем шест пъти. Последната зараза у нас е записана в интервала 1914 – 1918 година Тогава болестта е импортирано през Румъния, като за посочения интервал са регистрирани 845 инфектирани и 146 умряли.
Последният случай от холера в страната е регистриран през 1921 година и още веднъж е бил импортиран.
Благодарение на пречистването и хлорирането на питейната вода, по-късно болестта на практика е унищожено в Европа. Въпреки това броят на случаите на холера, докладвани на СЗО, продължава да бъде висок през последните няколко години, главно поради огнища в Африка и Южна Америка.
Става въпрос за 23-годишен индийски жител, живеещ у нас, който в интервала сред 13 август и 2 септември е бил в Ню Делхи, Индия, оповестяват от Министерството на здравеопазването.
За доказания случай рапортува столичната Регионална здравна ревизия (СРЗИ). Пациентът заболява на 3-ти септември заради остра диария, без демонстрация на други недоволства. Извършено е лабораторно проучване, което след това е доказано в Националната лаборатория по изключително рискови бактериални инфекции към Националния център по заразни и паразитни заболявания.
Заболелият е изолиран в стая със независим хигиеничен възел в СБАЛ по паразитни и инфекциозни заболявания „ Проф. Иван Киров “. Той е в положително общо положение.
Под наложителна карантина в същата болница е сложено и лице, с което болният съжителства, несъмнено от СРЗИ като непосредствен контактен. До момента той е без недоволства, като има негативен резултат от проучване и му е извършена антибиотична профилактика.
В хода на извършеното епидемиологично изследване няма открити други контактни лица.
Заболелият не е посещавал публични места, в това число заведения за хранене и други В лечебното заведение e връчено наставление за съблюдаване на прецизен противоепидемичен режим, засилена стерилизация, носене на персонални защитни средства от личния състав, за попречване разпространяването на болестта.
Холерата е извънредно заразно заболяване, излъчено посредством усвояване на нечиста храна или вода. Характеризира се с интоксикация, проваляне на тънкото черво, гастроинтестинални прояви, дехидратация, тежко протичане и висока смъртност.
Предаването на заболяването на хора става посредством консумация на инфектирана вода, храна и посредством нечисти ръце и предмети.
До началото на ХІХ век холерата е публикувана основно в Индия, като река Ганг е главният източник на болестта. От 20-те години на ХІХ век заболяването се популяризира и в други страни, като провокира пандемии с милиони жертви.
В България холерата е била сериозен проблем шест пъти. Последната зараза у нас е записана в интервала 1914 – 1918 година Тогава болестта е импортирано през Румъния, като за посочения интервал са регистрирани 845 инфектирани и 146 умряли.
Последният случай от холера в страната е регистриран през 1921 година и още веднъж е бил импортиран.
Благодарение на пречистването и хлорирането на питейната вода, по-късно болестта на практика е унищожено в Европа. Въпреки това броят на случаите на холера, докладвани на СЗО, продължава да бъде висок през последните няколко години, главно поради огнища в Африка и Южна Америка.
Източник: boulevardbulgaria.bg

КОМЕНТАРИ